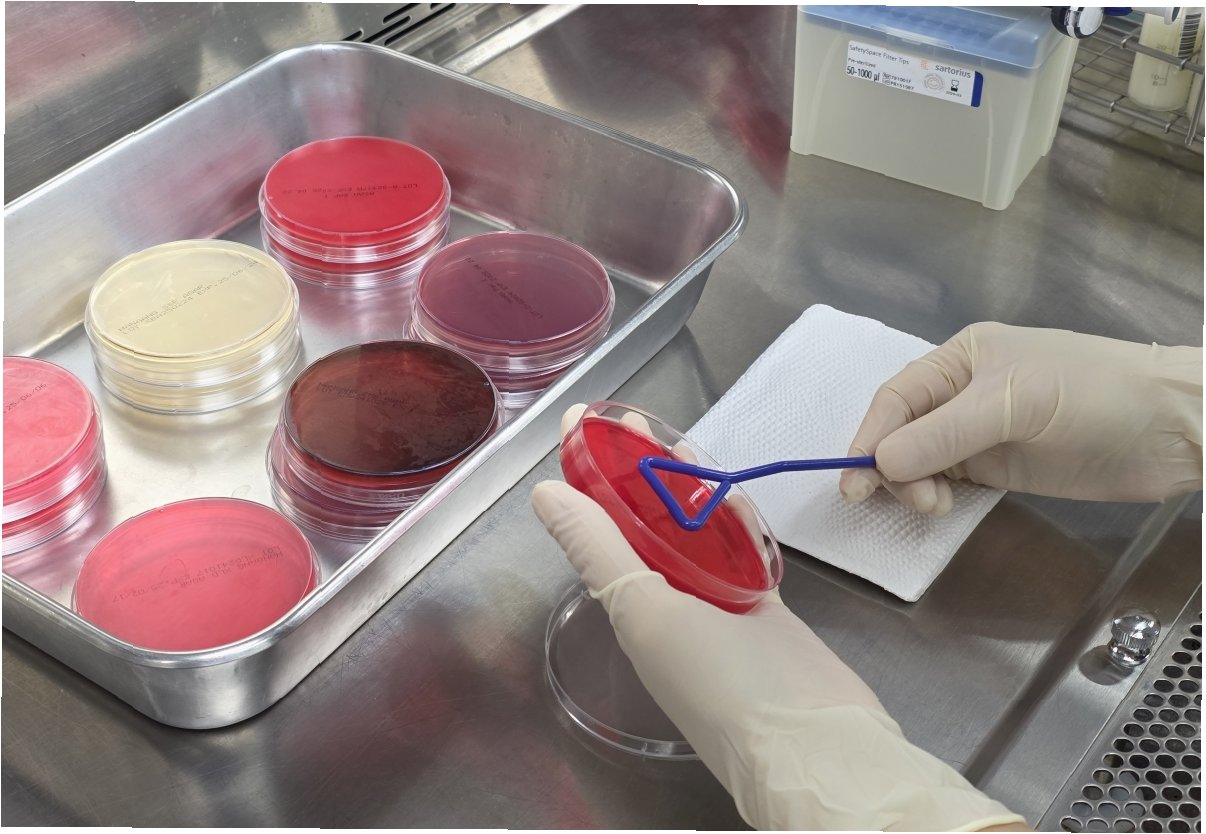

전남도의 '민심 회복' 프로젝트: 1인용 식탁부터 친절 앞치마까지, 어떤 변화를 만들까?
전남 여수, 불친절 논란의 중심
최근 전라남도 여수에서 발생한 음식점 불친절 및 숙박업소 위생 문제로 인해 여론이 악화되었습니다. 한 유튜버가 2인분을 주문하고 혼자 식사하는 모습에 식당 주인이 불쾌감을 표하거나, '걸레'라고 적힌 수건을 투숙객에게 제공하는 호텔의 위생 관리 소홀 등, 일련의 사건들이 공분을 샀습니다.

사과와 수습 노력, 그러나 싸늘한 여론
논란이 커지자 관련 업체들은 즉각 사과하며 수습에 나섰습니다. 하지만, 이미 싸늘하게 돌아선 여론은 쉽게 풀리지 않았습니다. 이러한 상황은 전라남도와 여수시의 이미지에 부정적인 영향을 미쳤고, 관광객 감소로 이어질 수 있다는 우려를 낳았습니다.

김영록 전남지사의 사과와 대책 발표
결국 김영록 전남지사가 직접 나서서 사과하며, 사태 해결을 위한 적극적인 의지를 표명했습니다. 그는 잇따른 불친절 문제와 위생 문제에 대해 깊이 사과하고, 실질적인 개선책을 제시했습니다.

위생 등급제, 안심 먹거리 존, 친절 앞치마
전라남도는 위생 관리를 강화하기 위해 위생 등급제 인증 업소를 중심으로 '특화 구역'을 지정하고, '안심 먹거리 존'을 조성할 계획입니다. 또한, '친절 앞치마'를 보급하여 서비스 품질 향상을 도모하고, 고령 자영업자를 위한 컨설팅을 제공하며, 잔반 재사용 금지 등 구체적인 방안을 추진할 예정입니다.

혼밥족을 위한 배려: 1인용 식탁 1,000개 보급
특히 주목할 만한 점은 '혼밥'이 가능한 음식점 확대를 위해 1인용 식탁 1,000개를 보급하겠다는 발표입니다. 이는 최근 증가하는 1인 가구 및 혼밥 문화에 대한 긍정적인 반응을 이끌어낼 것으로 기대됩니다.

대규모 국제 행사 앞둔 전라남도, 민심 회복에 총력
전라남도는 이달 말 전남국제수묵비엔날레를 시작으로 10월에는 미식 박람회, 골프대회, 국제농업박람회 등 대규모 국제 행사를 잇달아 개최할 예정입니다. 이러한 중요한 시기를 앞두고, 여수시는 시내 모든 음식점의 위생 상태와 친절도를 점검하며, 유튜브와 SNS를 통해 확산된 부정적인 여론을 돌리기 위해 적극적으로 노력하고 있습니다.

핵심만 콕!
전라남도는 최근 불거진 불친절 및 위생 논란을 잠재우기 위해, 도지사 사과와 함께 위생 등급제 강화, 친절 서비스 교육, 1인용 식탁 보급 등 다각적인 노력을 펼치고 있습니다. 다가오는 국제 행사를 성공적으로 개최하고, 긍정적인 이미지를 회복하기 위한 전라남도의 노력이 어떤 결실을 맺을지 귀추가 주목됩니다.
독자들의 Q&A
Q.전라남도의 개선책은 얼마나 효과적일까요?
A.위생 등급제 강화, 친절 교육, 1인용 식탁 보급 등 구체적인 방안들이 실질적인 변화를 가져올 수 있을지 지켜봐야 합니다. 특히, 1인용 식탁 보급은 혼밥 문화를 고려한 긍정적인 시도로 평가받고 있습니다.
Q.여수시의 노력은 어떤 방식으로 진행될까요?
A.여수시는 음식점 위생 및 친절도 점검을 강화하고, SNS를 통해 소통하며 부정적인 여론을 잠재우기 위해 노력할 것입니다. 긍정적인 변화를 이끌어내기 위한 적극적인 노력이 중요합니다.
Q.이번 사태가 전라남도 관광에 미치는 영향은 무엇일까요?
A.불친절 및 위생 문제는 관광객 감소로 이어질 수 있습니다. 전라남도의 적극적인 대처와 개선 노력을 통해 부정적인 영향을 최소화하고, 긍정적인 이미지를 회복하는 것이 중요합니다.
